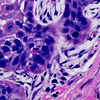

February 2019

Your spinal cord is 'smarter' than previously thought
Using specialized robotic technology, Andrew Pruszynski, PhD, and Jeff Weiler, PhD, demonstrated that the spinal cord is able to process and control complex functions, like the positioning of your hand in external space.
 Making connections in public health
Making connections in public health
Scanning more than 5,000 acres of wheat, soybeans, oats and corn, Jessica Schill sees public health in action. Her family’s farm in Palmerston, Ontario is a source of inspiration as she pursues her master’s degree, bringing experiences in agriculture and nursing to the Master of Public Health Program. Scientific discovery in unexpected places
Scientific discovery in unexpected places
Shawn Li, PhD, is driven by his curiosity. With many research questions and projects in the mix, he strives for clinical impact. “My ultimate goal for my career is to develop a drug or treatment strategy that can actually benefit patients.” Oral health research goes modern
Oral health research goes modern
Oral health problems have been called a “silent epidemic promoting the onset of life-threatening disease.” Douglas Hamilton, PhD, and Dr. Walter Siqueira are looking at ways to better protect oral health, prevent dental disease and intervene at earlier stages. Researchers committed to open-science efforts
Researchers committed to open-science efforts
Neuroscientists Tim Bussey, PhD, and Marco Prado, PhD, are giving labs around the world access to collective knowledge and technology in order to better understand the mouse brain. The hope is to come closer to unlocking the secrets of diseases like Alzheimer's. Graduate students: Make your voice heard
Graduate students: Make your voice heard
The Canadian Graduate and Professional Student Survey is your opportunity to provide feedback on your graduate program and student experience at Western. Watch your inbox for an email invitation from grad-survey@uwo.ca to complete the online, 15-minute survey by March 15. Tips for writing an op-ed
Tips for writing an op-ed
Interested in sharing your expertise and contributing to public debate? An op-ed is an opinion article on a timely news topic from an expert or specialist in a particular field. Read these tips on content and writing style, as well as things to consider when drafting and preparing your op-ed. CIHR grants support important projects from Indigenous health to cancer immunotherapy
CIHR grants support important projects from Indigenous health to cancer immunotherapy
Health researchers in London were awarded more than $10 million in funding from the Canadian Institutes of Health Research, with $7.3 million supporting projects through Schulich Medicine & Dentistry and $2.8 million through Lawson Health Research Institute. SchulichMedDent Live: Focusing on mental health
SchulichMedDent Live: Focusing on mental health
“Keep an open mind, open heart and open ears.” The most recent episode of SchulichMedDent Live featured Western's Global MINDS initiative. This interdisciplinary program focuses on mental health in Southwestern Ontario and around the world through sustainable partnerships with local community organizations. #SciComm: Every scientist should learn to make strong visual images
#SciComm: Every scientist should learn to make strong visual images
“We only see what we look at. To look is an act of choice.” Learning how to make technically accurate, interesting and honest images and graphics of science should be part of every scientist’s education. Via Inside Higher Ed Nature Career Column: Scientific progress is built on failure
Nature Career Column: Scientific progress is built on failure
“Failure is something all scientists experience - but it’s hard to tell, looking at our shiny conferences, polished presentations and glossy journals.” Via Nature Unique oncology internship builds research awareness and leadership skills
Unique oncology internship builds research awareness and leadership skills
The Oncology Research Internship (ORIoN) initiative in the Department of Oncology pairs resident mentors with medical students, providing an introduction to research and case reports. Share your #LHRD19 experience as a social media ambassador
Share your #LHRD19 experience as a social media ambassador
London Health Research Day is your opportunity to share, collaborate and learn with peers and research leaders. This year, we're taking the experience digital and we need your help. Share your #LHRD19 experience by becoming a social media ambassador for the event. Awards of Excellence: Nominations close February 25
Awards of Excellence: Nominations close February 25
Do you know a staff or faculty member that goes above and beyond? Help us recognize the teachers, mentors and leaders making a difference in your area. Submit your Awards of Excellence nomination online by February 25. Petro-Canada Young Innovator Awards 2019
Petro-Canada Young Innovator Awards 2019
The Petro-Canada program provides two awards to new researchers at Western ($16,000) and Robarts ($11,000) to recognize, promote and support work that is particularly innovative, impacts positively on the learning environment in their department, and has the potential to be of significance to society at large. Apply by March 25. 2019 Award for Outstanding Graduate Mentorship
2019 Award for Outstanding Graduate Mentorship
Mentors are essential to graduate student success - in the classroom, laboratory and beyond. The Canadian Association for Graduate Studies showcases the work of faculty members with a record of outstanding mentorship of graduate students under their supervision.- Celebrating your recent achievements
Congratulations to Timothy Scholl, Mihai Dumbrava, Milica Krstic, as well as many others, on your recent accomplishments. - Featured publications
Featured publications covering topics ranging from how exercise may protect against Alzheimer's to human cytoplasmic tRNAs to obesity in total knee arthroplasty. Authors include Jeremy Lant, Jamie Seabrook, Edward Vasarhelyi and more. - Beyond the Bench
From #WomenInSTEM to front page news to a #frostbike selfie, take a look at what your colleagues have been up to this month. Tweets from Natasha Knier, Andrew Pruszynski, Marco Prado and more.


